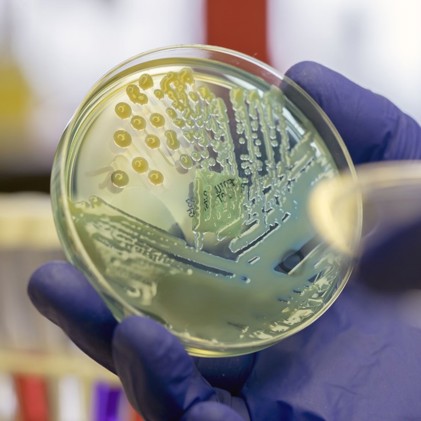

This topic takes on average 55 minutes to read.
There are a number of interactive features in this resource:
 Biology
Biology
Preventable infectious disease is estimated to cause two thirds of child deaths and, in 2008, more than 9.5 million people died of infectious disease.

A vaccine to prevent spread of H1N1influenza
was developed rapidly by pharmaceutical companies.
Learn more about microbes which cause disease on this Society for General Microbiology site:
Visit Microbiology Society website